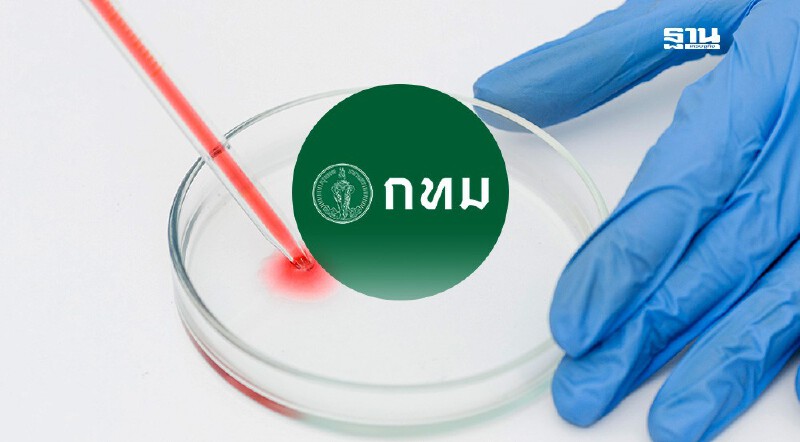
.มัดรวมพิกัดตรวจโรคซิฟิลิส 2568 ทั่ว กทม. 31 แห่ง อัปเดตที่นี่.

คาถาหลวงปู่ศุข เมตตามหาเสน่ห์ เดินทางแคล้วคลาดปลอดภัย

เปิดคาถาจากเกจิอาจารย์ชื่อดัง หลวงปู่ศุข วัดปากคลองมะขามเฒ่า จ.ชัยนาท ที่หลายคนให้ความเสื่อมใสโดยเป็น คาถาเมตตามหาเสน่ห์ และคาถาเดินทางแคล้วคลาดปลอดภัย
คาถาเมตตามหาเสน่ห์
ตั้งจิตภาวนา ตั้งนะโม 3 จบ และกล่าว
- อักโขหะมัสสะมิ โลกัสสะ อิติปาระมิตาติงสา อิติสัพพัญญูมาคะตา อิติ โพธิมะนุปัตโต อิติปิโส จะ เต นะโม อะระหัง ลาโภ พุทโธ ลาภัง นะชาลีติ นะมะพะทะ สัพเพ ชะนา พหู ชะนา ราชาปุริโส อิตถิโยมาพัง เอหิ จิตตัง ปิยัง มะมะ เอหิ มาเร โส มามา อาคัจเฉยยะ อาคัจฉาหิ
คาถาเดินทางแคล้วคลาดปลอดภัย
ตั้งจิตภาวนา ตั้งนะโม 3 จบ และกล่าว
- สัตถา เทวะมะนุสสานัง พุทโธ ภะคะวาติ มะอะอุ

สำหรับพระครูวิมลคุณากร หรือ หลวงปู่ศุข วัดปากคลองมะขามเฒ่า อ.วัดสิงห์ จ.ชัยนาท เป็นอีกหนึ่งพระเกจิอาจารย์ชื่อดังที่หลายคนให้ความเลื่อมใส ว่าท่านมีวิชาอาคม วัตถุมงคลและเครื่องรางก็มีพุทธคุณสูงมาก แม้ว่าหลวงปู่ศุขจะละสังขารมากว่า 100 ปีแล้ว แต่ก็ยังมีผู้เสื่อมใสศรัทธา และได้มีการสร้างรูปหุ่นขี้ผึ้งไว้ที่วัดปากคลองมะขามเฒ่า ให้ผู้คนได้เข้าไปสักการะที่ จ.ชัยนาท
แหล่งข้อมูล:คาถาหลวงปู่ศุข เมตตามหาเสน่ห์ เดินทางแคล้วคลาดปลอดภัย












.jpg?ip/crop/w1200h700/q80/jpg)




.jpg?ip/crop/w1200h700/q80/jpg)